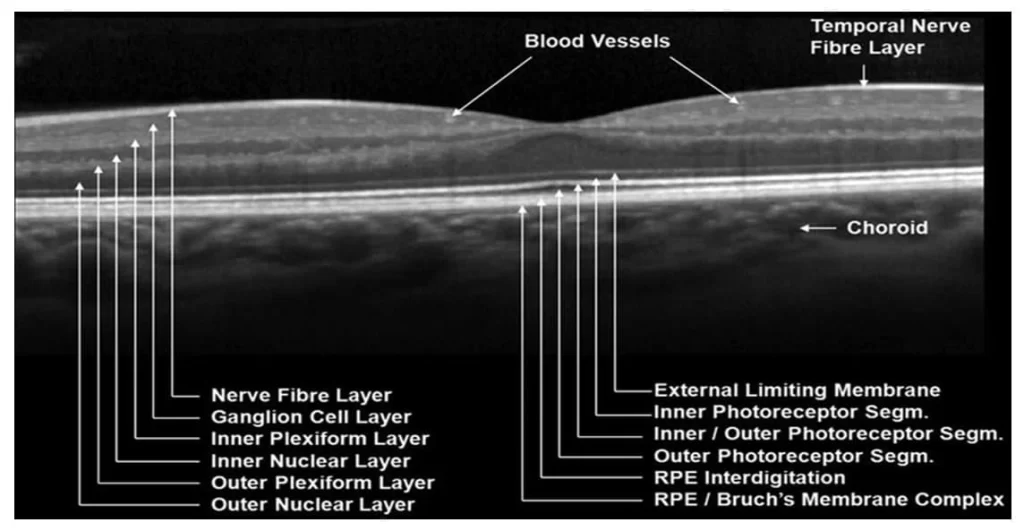

Retinal imaging is to take pictures of your retina i.e, back of your eye. Imaging is done using different techniques as per the diagnosis. Most common techniques are: Optical coherence tomography, Fundus photography, Angiography. Imaging plays an essential role in diagnosing several pathologies such as diabetic retinopathy, hypertensive retinopathy and age-related macular degeneration.
Imaging helps your doctor to detect the earlier/subtle changes of retinal diseases which cannot be identified on routine eye examination. Early detection of diseases helps to treat the disease properly. Imaging also makes easier for your doctor to educate you and your family members about your condition. And it helps in monitoring the progression of the disease and comparing them with future images.


A dye based study of retinal and choroidal circulation.

Similar to fundus fluorescein angiography using indocyanine green dye and delineates choroidal circulation better.

Fast and comfortable technology to obtain a Panoramic view of the retina

A diagnostic tool based on ultrasound to obtain a 2 dimensional ,cross-sectional image of the eyeball and the orbit.

Ultrasound based imaging of anterior segment of the eye.
A non invasive light wave based imaging to obtain the cross section of retina

A non invasive technology to visualise blood vessels down to capillary level

Visual Electrophysiological Testssuch as ERG, multifocal ERG, EOG and VEP-A set of tests to assess the visual conduction from the photoreceptors to the visual cortex of brain.